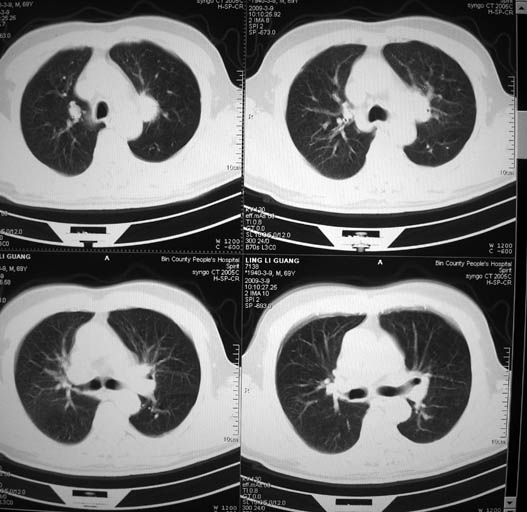
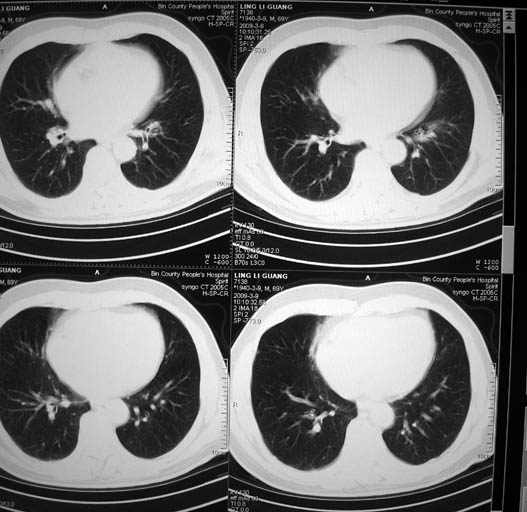

以下是引用随光逐影在2009-3-9 21:36:00的发言:[br]1)两肺上叶尖段结节状病灶,性质待定(不排除肿瘤可能);建议追踪复查。2)右肺中叶内侧段炎症。
以下是引用杀毒软件在2009-3-9 21:12:00的发言:[br]考虑---陈旧肺结核----定期复查
以下是引用随光逐影在2009-3-9 21:36:00的发言:[br]1)两肺上叶尖段结节状病灶,性质待定(不排除肿瘤可能);建议追踪复查。2)右肺中叶内侧段炎症。
以下是引用随光逐影在2009-3-9 21:36:00的发言:[br]1)两肺上叶尖段结节状病灶,性质待定(不排除肿瘤可能);建议追踪复查。2)右肺中叶内侧段炎症。
| 欢迎光临 医影在线 (http://bbs.radida.com/bbs/) | Powered by Discuz! X3.2 |